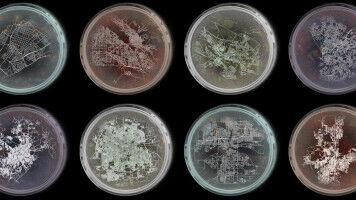
Cities obey the same laws of living systems

news
Swiss Federal Institute of Technology Lausanne, EPFL
Results 41 - 60 of 1375.
Life Sciences - 12.09.2025

Biologists have long known that amino acids can help stabilize proteins, for example as additives to pharmaceutical formulations. In trying to understand why this works, EPFL and MIT researchers have discovered a fundamental stabilizing effect of all small molecules, creating exciting possibilities for controlling particles in solution.
Health - Life Sciences - 10.09.2025

From robotic hands and arms to soft heart pumps, biomaterials, 3D-printed muscles and more, rapid advancements in robotics and biotechnology are giving rise to new techniques for repairing the human body.
Health - Life Sciences - 09.09.2025

Scientists have shown that a gene linked to a rare childhood disease is essential for regenerating intestinal stem cells after injury. Our intestines are constantly renewing themselves, replacing cells every few days to maintain a healthy gut lining. But when injury strikes, the body needs to reboot this system fast.
Life Sciences - 29.08.2025

Since its release last year, the open-source platform BindCraft, developed at EPFL, has already disrupted the world of protein design. Physical interactions between proteins influence anything from cell signaling and growth to immune responses, so the ability to control these interactions is of great interest to biologists.
Life Sciences - 28.08.2025
Advanced AI models are not always better than simple ones
Researchers have developed Systema, a new tool to evaluate how well AI models work when predicting the effects of genetic perturbations. Understanding how genetic perturbations, when scientists intentionally alter genes to see how this affects cells, is key to understanding what our genes do and how they are controlled.
Life Sciences - 28.08.2025
Mapping the brain's wiring
Researchers have developed a powerful method to generate brain-wide, biologically realistic wiring maps of the mouse brain. Their approach bridges experimental data with mathematical and computational modeling to simulate how neurons connect across the entire brain. One of neuroscience's greatest challenges is understanding how the brain is wired.
Life Sciences - 27.08.2025

Researchers at EPFL and the University of Geneva have developed a new algorithm that cracks an outstanding challenge in network science: dealing with directionality to detect communities. From neuroscience to social media and traffic patterns, this breakthrough reveals not just who's connected-but who's leading the pack.
Health - 26.08.2025

Scientists from EPFL and Haute École d'Ingénierie et de Gestion du Canton de Vaud (HEIG-VD), working in partnership with the City of Yverdon-les-Bains, have analyzed the sleep quality of a sample of the city's residents. They discovered that sleep disorders are much more common there than elsewhere in the country.
Environment - Life Sciences - 21.08.2025
An EPFL study has found that urban areas follow the same universal rules observed in the natural world. From population size to carbon emissions and road networks - could the key to sustainable urbanization lie in the very "metabolism" of our cities? Since the rise of Western megacities, novelists have often likened the city - and its productive systems - to a living organism.
Astronomy & Space - 19.08.2025

EPFL and Max Plank researchers use satellite Gaia's data to map 35,000 variable stars in 1,200 star clusters, revealing new ways to track the lives of stars. One of the best places to study stars is inside "open clusters", which are groups of stars that formed together from the same material and are bound together through gravity.
Physics - 05.08.2025

Researchers have developed a new imaging method, based on the use of a single-photon camera, that can characterizes thousands of molecules quickly and simultaneously. The new method, inspired by an imaging technique that has been around for 35 years, takes ultraprecise measurements of a molecule's unique light-emission signature at the scale of a billionth of a second.
Physics - Innovation - 04.08.2025

Researchers at EPFL and Harvard University have engineered a chip that can convert between electromagnetic pulses in the terahertz and optical ranges on the same device. Their integrated design could enable the development of devices for ultrafast telecommunications, ranging, spectroscopy, and computing.
Life Sciences - Health - 31.07.2025

Researchers at EPFL have discovered how the structure of DNA packaging in cells determines which proteins can interact with the key tumor suppressor p53. Each cell in our bodies carries about two meters of DNA in its nucleus, packed into a tiny volume of just a few hundred cubic micrometers-about a millionth of a milliliter.
Life Sciences - Health - 24.07.2025

Researchers have developed a 'self-driving' microscope that can predict the onset of misfolded protein aggregation - a hallmark of neurodegenerative disease - as well as analyze the biomechanical properties of these aggregates. The accumulation of misfolded proteins in the brain is central to the progression of neurodegenerative diseases like Huntington's, Alzheimer's and Parkinson's.
Computer Science - Life Sciences - 22.07.2025

A study from EPFL reveals why humans excel at recognizing objects from fragments while AI struggles, highlighting the critical role of contour integration in human vision. Every day, we effortlessly recognize friends in a crowd or identify familiar shapes even if they are partly hidden. Our brains piece together fragments into whole objects, filling in the blanks to make sense of an often chaotic world.
Chemistry - 21.07.2025

Researchers have created a uranium catalyst that converts nitrogen gas into ammonia using a unique binding method, potentially offering insights into more sustainable fertilizer production. Ammonia (NH3) is vital for agriculture, as it is the basis for fertilizers that are needed to feed the world's population.
Microtechnics - Innovation - 17.07.2025

Researchers have pioneered a 3D-printable, programmable lattice structure for robotics that mimics the vast diversity of biological tissues - from a flexible trunk to rigid bone - using a single foam material. A cheetah's powerful sprint, a snake's lithe slither, or a human's deft grasp: each is made possible by the seamless interplay between soft and rigid tissues.
Physics - Chemistry - 16.07.2025

By leveraging the concept of chirality, or the difference of a shape from its mirror image, scientists have engineered an optical metasurface that controls light to yield a simple and versatile technique for secure encryption, sensing, and computing. Imagine trying to wear a left-handed glove on your right hand: it doesn't fit because left and right hands are mirror images that can't be superimposed on each other.
Physics - Chemistry - 11.07.2025
New liquid can simplify hydrogen transportation and storage
Researchers at EPFL and Kyoto University have created the first hydride-based deep eutectic solvent-a stable hydrogen-rich liquid formed by mixing two simple chemicals. This breakthrough could make hydrogen storage easier, safer, and more efficient at room temperature. Hydrogen can be the clean fuel of the future, but getting it from the lab to everyday life isn't simple.
Life Sciences - Environment - 08.07.2025

At more than 470 times the atmospheric concentration of CO2, a humble soil bacterium does something extraordinary: it turns gas into stone.
Pharmacology - Today
GSK, University of Oxford and Imperial College London launch centre to create computer models of lungs, liver, kidneys and cartilage
GSK, University of Oxford and Imperial College London launch centre to create computer models of lungs, liver, kidneys and cartilage

Innovation - Today
India's new wave of Hindu Religious Entrepreneurship is reshaping our interpretation of success
India's new wave of Hindu Religious Entrepreneurship is reshaping our interpretation of success
Veterinary - Today
New RVC study challenges common beliefs on desirable behaviours in designer 'Doodle' crossbreeds
New RVC study challenges common beliefs on desirable behaviours in designer 'Doodle' crossbreeds

Agronomy & Food Science - Today
Bird Flu Risk to Danish Cattle - New Tool Can Warn Farmers Before Infection Spreads
Bird Flu Risk to Danish Cattle - New Tool Can Warn Farmers Before Infection Spreads
Chemistry - Today
Leipzig University and Center for the Transformation of Chemistry conclude collaboration agreement
Leipzig University and Center for the Transformation of Chemistry conclude collaboration agreement

Psychology - Today
Analysis: Trying your best in a second language? Here's why native speakers seem so rude
Analysis: Trying your best in a second language? Here's why native speakers seem so rude
Computer Science - Mar 18
SDU is part of global initiative to bring mathematical certainty to modern computing and artificial intelligence
SDU is part of global initiative to bring mathematical certainty to modern computing and artificial intelligence







